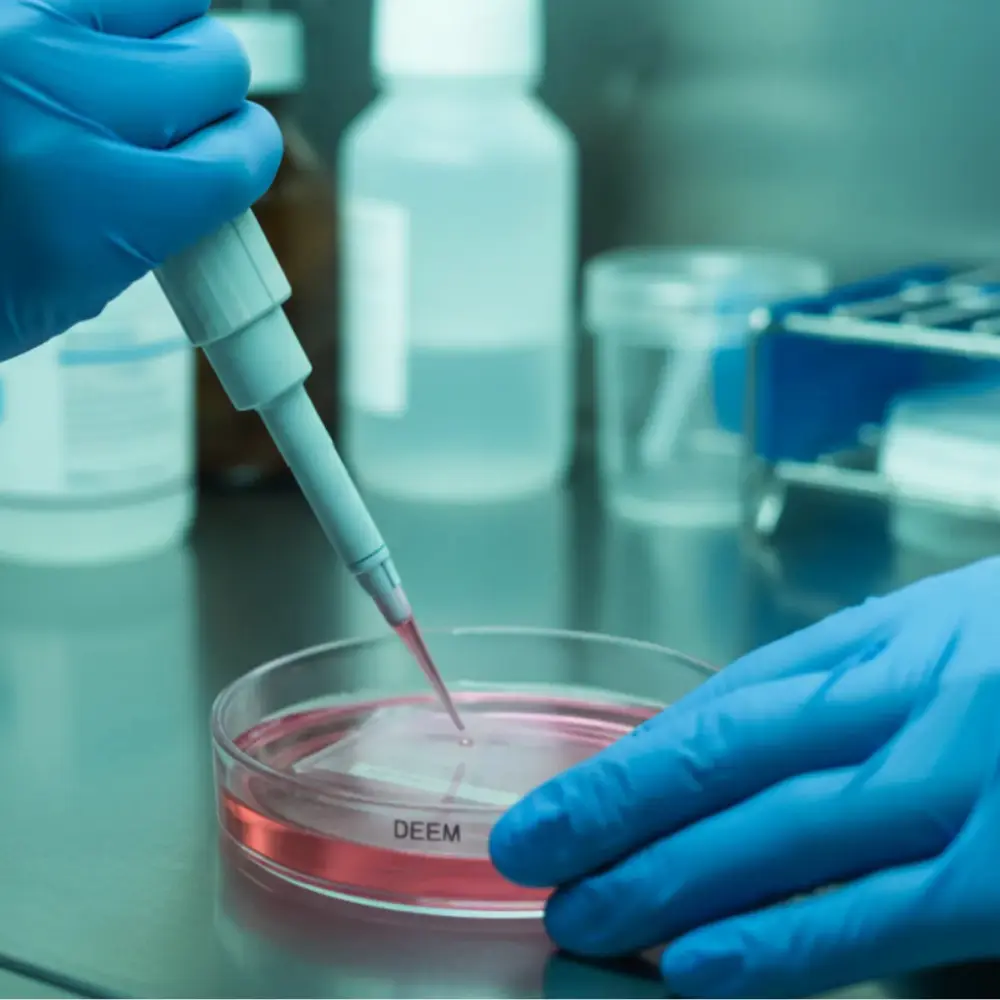

Cellralis
- Anasayfa
- Hizmetlerimiz
Cellralis
Cellralis, standart laboratuvar testlerinin ötesine geçerek akademik yayınlarınız ve projeleriniz için bilimsel çözümler üretir. Sitotoksisite analizlerinden moleküler mekanizma takibine kadar tüm süreçleri, doz-yanıt ilişkisini ve biyolojik etkiyi netleştirecek şekilde kurguluyoruz. Elde edilen verileri, projelerinizde doğrudan entegre edilebilecek, metodolojik olarak güçlü ve bütünlüklü bir sonuç raporu halinde sunuyoruz.
Yaşamın Temeline Bilimsel Dokunuş.
